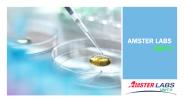
3rd Party Manufacturing Pharmaceuticals In India

File to download:
Title: 3rd Party Manufacturing Pharmaceuticals In India - PowerPoint PPT Presentation
Description: Amster labs joined the pharmacy and drug processing sector more than 8 years ago. When the India administration decided to promote the development of 3rd Party Manufacturing Pharmaceuticals In India to set up an excise region in Baddi, we also took the opportunity to set up our ultra-modern plant in Baddi, among many other pharmaceutical manufacturers. One of Baddi India's fast-growing third-party pharmaceutical firms, we are considered to be a 3rd Party Manufacturing Pharmaceuticals In India. We include ALL Parts UNDER ONE ROOF in Baddi to third party drug producers. We are an ISO, GLP and GMP-certified pharmaceuticals business, which ensures that any time you put an order you get consistent consistency. You don't have to think about variations in consistency. Copies with standard certifications can be downloaded on the website. – PowerPoint PPT presentation
Download instruction:
When the PPT version of this presentation was uploaded to PowerShow.com, it was checked for
viruses. That said, we cannot guarantee that the PPT file is safe for you to download. But if you
whish to download it, just check that you are not a robot and then click the download button.